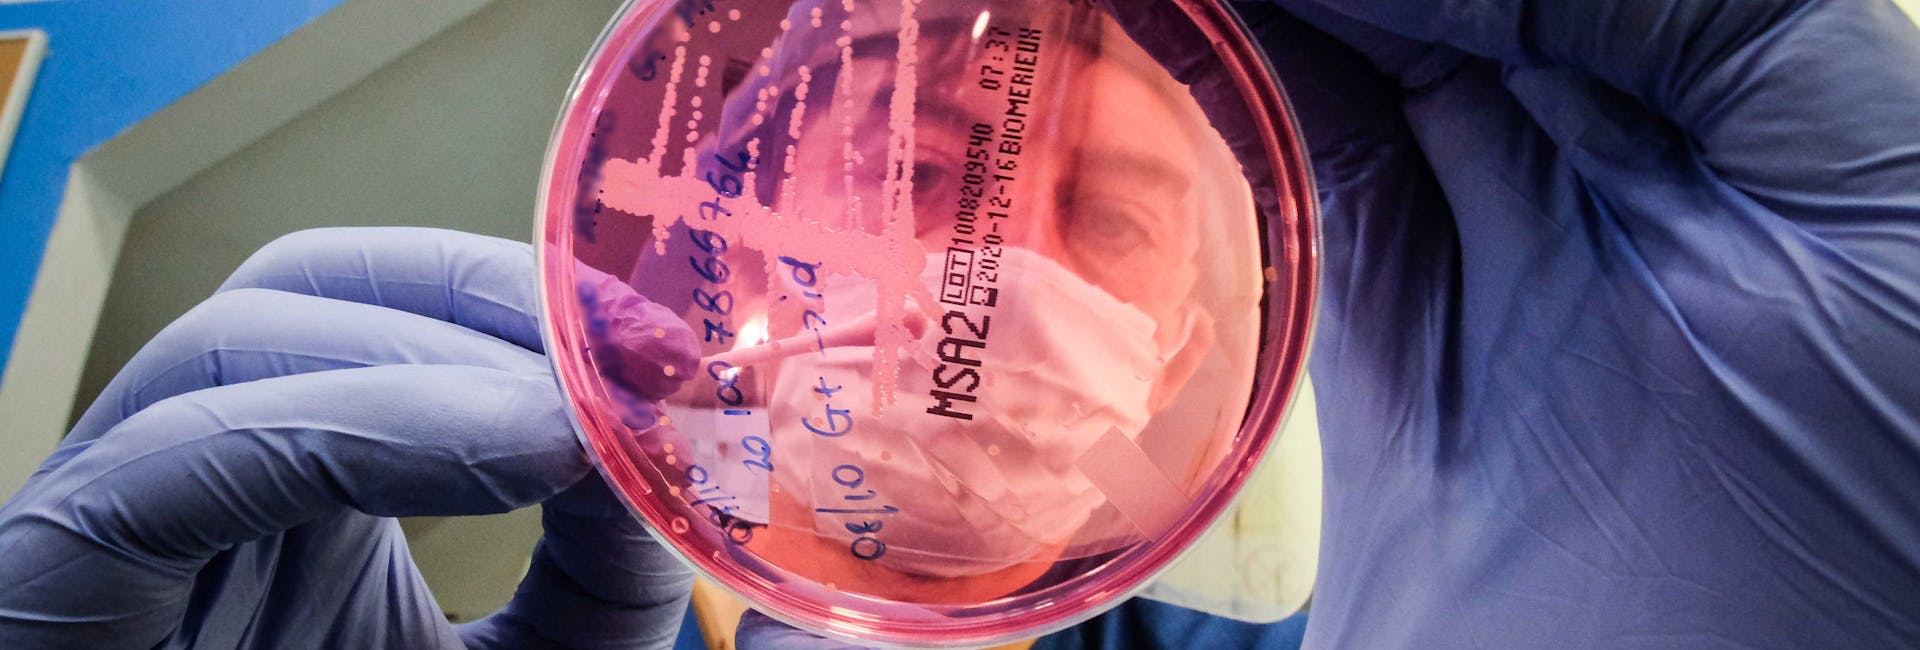

Infermeria
,Oumy Diaw
Servizi Ausiliari

Oumy si occupa del decoro, della disinfezione e dell'ordine di tutti gli ambienti del Vet Hospital sin dal 2017.
Oumy è una parte fondamentale del team perché permette ai medici di svolgere l'attività clinica in accordo ai migliori standard di disinfezione e prevenzione delle contaminazioni, aspetto fondamentale nella cura dei nostri pazienti.

STAFF
Scopri gli altri membri

Infermeria,
Dott.ssa Luciana Camarda
Capo Infermiera

Infermeria,
Niccolò Dainelli
Infermiere

Infermeria,
Dott.ssa Martina Giorgetti
Infermiera

Infermeria,
Dott.ssa Beatrice Parronchi
Infermiera

Infermeria,
Elisa Benichi
Infermiera

Infermeria,
Martina Loi
Infermiera

Infermeria,
Eleonora Mantelli
Infermiera

Infermeria,
Michela Meli
Infermiera

Infermeria,
Arsene Brou
Servizi Ausiliari